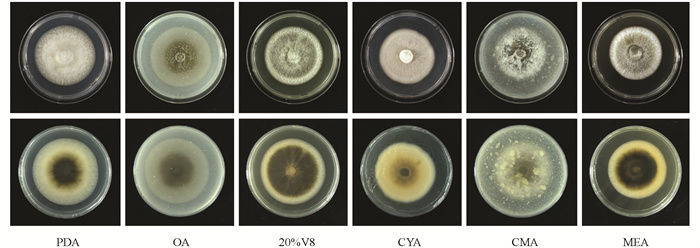

-
开放科学(资源服务)标识码(OSID):

-
近年来,由于耕作制度、气候条件、烟草品种和栽培方式的改变,以及烟田连作年限延长,导致烟草叶斑类病害逐年加重[1]。烟草叶斑病因流行范围广,持续时间长,混生病多不易区分,给当地的烤烟质量和产量造成重大损失[2]。
目前,对于烟草叶斑病的防治仍然以化学药剂为主。烤烟打顶后至采收完成,叶部病害大面积发生,主要病害包括马铃薯Y病毒病、赤星病、野火病等[3]。防治化学药剂的选择和施用多参考主要病害的用药,生产上常选用10%苯醚甲环唑水分散粒剂[4]、80%代森锰锌可湿性粉剂、430 g/L戊唑醇悬浮剂[5]、450 g/L咪鲜胺水乳剂[6]、80%波尔多液可湿性粉剂[7]、8%井冈霉素可溶液剂[8]等,在一定程度上能够控制烟草叶斑病的发生和发展,但是施用同种药剂不能有效防治多种病原菌引起的叶部病害。长期不规范使用化学农药一方面会导致病原菌产生抗药性,另一方面也导致一些对常规化学药剂不敏感的以子囊菌门(Ascomycota)真菌为主要病原的新病害逐渐上升为主要病害。2020年以来,在我国各烤烟产区,一些由Epicoccum sp. [9],Didymella segeticola[10],Cumuliphoma indica[11],Stagonosporopsis vannaccii[12]等在内的多种病原菌引起的烟草叶斑类新病害和新病原不断被发现,并呈现出危害加重的趋势,且不同地区之间病原种类不一。
本研究前期从陕西省宝鸡市陇县秦烟99烟田发现了一种新型烟草叶斑病,病斑不规则形,褐色,杂有不规则的白色斑,常造成叶尖和叶缘破碎。不同于其他烟草叶斑病,该病原主要危害烟叶的叶尖或叶缘部位,部分病斑边缘呈“锯齿”状。在生产上常不被重视,多被误认为是虫害。在发病环境适宜时,若不依据该病害的病原为靶标选择药剂加以防治,易造成流行,给烟叶生产带来巨大的损失,因此,为更好地防治该病害,需明确引起该叶斑病的病原种类和适宜的生存环境。病原菌经组织分离、纯化后,进行致病性测定,结合形态学和分子生物学手段进行鉴定,并研究该菌的生物学特性,旨在为该病害的防治提供理论依据。
全文HTML
-
烟草品种:秦烟99,由陕西省宝鸡市陇县曹家湾镇盛大烤烟专业合作社提供。
供试病样:采集自宝鸡市陇县曹家湾镇三里营村。
供试培养基:马铃薯葡萄糖琼脂(PDA)培养基,燕麦琼胶(OA)培养基(燕麦片30 g加水1 000 mL,煮沸1 h,用纱布过滤后补足水至1 000 mL,加入琼脂粉20 g),20%V8培养基(V8汁离心后取澄清液200 mL,碳酸钙(CaCO3)0.2 g,琼脂粉20 g,蒸馏水1 L),察氏酵母膏琼脂(CYA)培养基,玉米粉琼胶(CMA)培养基,麦芽浸膏琼脂(MEA)培养基,察氏(CZA)培养基[13]。以上培养基用250 mL锥形瓶分装,100 mL/瓶,121 ℃下灭菌25 min。
-
选取田间具有典型症状的烟草叶片进行拍照,并详细描述烟草叶斑病的发病症状。参照《植物病理学实验技术》中组织分离法[14]对采集的新鲜病样进行分离,剪去若干病组织(发病症状较轻的病斑病健交界处)5 mm×5 mm,放入70%酒精中表面消毒10 s,然后再置于3%次氯酸钠溶液中消毒3 min,后用无菌水漂洗3次,用无菌滤纸吸干水分,置于加有硫酸链霉素的PDA平板上,每个平板摆放5块,10次重复。倒置于25 ℃恒温培养箱中全黑暗培养,5 d后,将分离株单菌落编号,4 ℃冰箱保存。
-
离体叶片针刺接种法[15]:选取5~6叶期烟草叶片,消毒后用湿润的无菌棉包裹基部,放入培养皿中,将烟草叶片用一次性注射器针头刺穿,而后将菌饼贴在伤口上,将培养皿封口,置25 ℃温室内保湿培养,以接种PDA培养基菌饼为对照。活体叶片注射接种法:在8~10叶期烟草中部叶片选取3点注射2 μL的分离株孢子悬浮液(1×108个/ mL),置25 ℃,14 h光照/10 h黑暗温室保湿培养24 h,而后将保湿盖摘掉在温室内继续培养,以接种等量无菌水为对照,按相同方法进行接种,观察记录发病情况,待叶片发病后,采用组织分离法于病健交界处再次分离,确定分离株是否为致病菌。
-
将代表性菌株BAN1在PDA培养基上25 ℃恒温培养7 d,观察记录烟草叶斑病病原菌的菌落形态。在加有灭菌烟草茎秆的PDA培养基上培养病原菌,待其分生孢子器等结构产生后,描述并测量分生孢子器和分生孢子的形态与大小。
-
利用真菌基因组DNA提取试剂盒提取病原菌DNA,通用引物ITS1/ITS4[16]、LORO/LR5[17-18]、TUB-2Fd/TUB-4Rd[19]分别对病原菌的核糖体内转录间隔区(ITS)、核糖体大亚基(LSU)和β-微管蛋白基因(TUB2)的片段进行PCR扩增,引物均由陕西擎科生物科技有限公司合成。PCR产物经1%琼脂糖凝胶电泳检测,将合格扩增产物送至陕西擎科生物科技有限公司进行测序。测序结果在NCBI中进行BLAST比对,从GenBank下载Phoma属近缘种的ITS、LSU、TUB2基因序列作为参考序列。利用MEGA 9.0软件对上述基因序列进行比对分析,序列两端切齐后,按照ITS-LSU-TUB2顺序首尾相连,以最大似然法构建系统发育树,重复检验1 000次。
-
将烟草叶斑病病原菌8 mm的菌饼分别接种于直径90 mm的PDA、OA、20%V8、CYA、CMA、MEA培养基中央,25 ℃全黑暗培养,测定不同培养基对病原菌生长的影响。采用PDA培养基,设置7个温度梯度:5、10、15、20、25、30、35 ℃,以确定不同温度对病原菌生长的影响;同时测定病原菌的致死温度,分别于45、46、47、48、49、50 ℃水浴处理10 min,接种于PDA平板上培养,以病原菌菌丝不生长的温度为致死温度。用1 mol/L的NaOH溶液和HCl溶液将灭菌后的PDA培养基调至3、4、5、6、7、8、9、10、11、12共10个pH梯度,以确定不同pH值对病原菌生长的影响。设置全光照、全黑暗、12 h/12 h光暗交替3个光照处理,以确定不同光照条件对病原菌生长的影响。采用察氏培养基为基础培养基,测定不同碳源(以硝酸钾为氮源,以葡萄糖、果糖、麦芽糖、淀粉、乳糖、山梨醇为碳源替换其中的蔗糖并设置无碳处理作为对照,25 ℃全黑暗培养)、不同氮源(以蔗糖为碳源,以蛋白胨、草酸铵、苯丙氨酸、甲硫氨酸、酵母粉、硫酸铵等替换其中的硝酸钾并设置无氮处理作为对照,25 ℃全黑暗培养)对病原菌菌丝生长的影响。
在PDA平板上培养5 d的烟草叶斑病病原菌的菌落边缘打取直径为8 mm的菌饼,在无菌条件下将其接种于直径90 mm的各处理平板中央,置于恒温培养箱中培养7 d后采用十字交叉法测量菌落直径,计算菌丝平均生长速率,每个处理4次重复。
-
采用Excel 2013和SPPS 19.0软件对数据进行统计分析,Duncan氏新复极差法进行各处理间的差异显著性检验。
1.1. 供试材料
1.2. 试验方法
1.2.1. 病组织分离与分离物纯化
1.2.2. 分离物致病性测定
1.2.3. 病原菌的形态学鉴定
1.2.4. 病原菌的分子生物学鉴定
1.2.5. 病原菌的生物学特性测定
1.3. 数据分析
-
于2023年8月5日在秦烟99烟草田(5月1日移栽)发现新病害,田间发病率为20%。该病主要危害烟草叶缘和叶尖,病斑形状不规则,灰褐色,边缘具有明显的黄绿色晕圈,伴生不规则的白色斑,后期叶尖和叶缘呈“锯齿状”,病斑易“穿孔”破碎,开裂脱落(图 1)。
-
采用离体叶片针刺接种法接种代表性分离株BAN1菌饼4 d后,接种处坏死,产生水渍状病斑,对照叶片不发病(图 2a)。采用活体叶片注射接种法接种分离株孢子悬浮液7 d后,叶尖接种处坏死,而用无菌水处理的叶片保持健康(图 2b)。根据柯赫氏法则,对发病叶片再分离,所得菌株菌落形态与接种菌株一致,确定分离株BAN1为该烟草叶斑病的病原菌。
-
菌株BAN1活化后,25 ℃黑暗培养7 d,在PDA平板上的平均生长速率为(7.15±0.25)mm/d,菌落近圆形,菌丝茂密、白色至灰白色,菌落背面中间黑色,黄褐色,边缘白色(图 3a、3b)。随着培养时间的延长,菌落颜色逐渐变成黄棕色。在加入灭菌烟草茎秆的PDA平板上诱导病菌产孢,产孢结构生于菌落边缘或烟草茎秆表面(图 3c),分生孢子器暗褐色、球形,(141.8~236.2) μm×(190.9~246.6) μm(图 3d、3e);后期在分生孢子器表面分泌大量白色“脓状物”,其为大量的分生孢子。分生孢子无色、单胞、梭形、瓜子形、芝麻形,(2.4~3.0) μm×(3.6~6.8) μm(图 3f)。
-
为了准确鉴定该物种,提取代表性菌株BAN1的基因组DNA,联合ITS、LSU和TUB2多基因构建系统发育树。由图 4可知,该菌株与Phoma bulgarica聚在一支。结合形态学鉴定,最终将菌株BAN1鉴定为Phoma bulgarica。
-
由图 5可知,最适于烟草叶斑病病原菌菌丝生长的培养基为PDA培养基和OA培养基,菌丝的平均生长速率分别为7.33 mm/d、7.30 mm/d,二者差异无统计学意义。菌株BAN1的菌落在不同培养基上呈规则圆形,菌落颜色和菌丝茂密程度不同。在OA培养基和CMA培养基上,菌丝生长较为稀疏(图 6)。
-
由图 7可知,该菌在5~35 ℃内均能生长,最适宜菌丝生长的温度为25 ℃,在该温度条件下菌丝的平均生长速率为7.07 mm/d;当温度为20 ℃时有利于病原菌的生长,菌丝平均生长速率为5.21 mm/d,与其他处理差异显著;当温度低于10 ℃或高于30 ℃时菌丝生长速度缓慢或不生长。病原菌菌饼经过46 ℃及以上温度恒温水浴处理10 min后再培养,菌丝完全没有生长,确定该病原菌菌丝的致死温度为46 ℃、水浴10 min。
-
烟草叶斑病病原菌在pH值为3~12内均能生长,表明该病原菌对酸碱耐受性强。从图 8可以看出,该病原菌对碱性环境敏感,更适宜在酸性环境下生长。最适宜菌丝生长的pH值为5,该条件下菌丝的平均生长速率为7.25 mm/d。pH值在3~8时,对病原菌生长水平的影响没有统计学意义。在碱性环境下,随着pH值的升高,病原菌菌丝的生长速率呈现减缓趋势。
-
由图 9可知,该病原菌在3种不同光照环境下均可生长。全黑暗条件下病原菌菌丝平均生长速率为7.37 mm/d,与其他处理差异有统计学意义,为最适光照条件。
-
由图 10可知,烟草叶斑病病原菌在供试的6种碳源察氏培养基上均可以正常生长,而在无碳源的对照培养基上菌丝稀疏,生长异常。不同碳源对该病原菌生长的影响较大,最适宜病原菌菌丝生长的碳源为淀粉,在该条件下菌丝的平均生长速率为5.75 mm/d;其次是果糖,菌丝的平均生长速率为5.06 mm/d,与其他处理差异有统计学意义。
-
由图 11可知,6种供试氮源均可以被病原菌利用,菌丝生长速率显著高于无氮对照。苯丙氨酸最适宜病原菌菌丝的生长,其平均生长速率为6.94 mm/d;蛋白胨、草酸铵、硫酸铵次之,其平均生长速率分别为6.50、6.44、6.38 mm/d,与其他处理差异有统计学意义。
2.1. 烟草叶斑病田间发病症状
2.2. 分离株BAN1的致病性测定
2.3. 烟草叶斑病病原菌的形态学鉴定
2.4. 烟草叶斑病病原菌的分子生物学鉴定
2.5. 不同培养基对烟草叶斑病病原菌菌丝生长的影响
2.6. 不同温度对烟草叶斑病病原菌菌丝生长的影响
2.7. 不同pH值对烟草叶斑病病原菌菌丝生长的影响
2.8. 不同光照条件对烟草叶斑病病原菌菌丝生长的影响
2.9. 不同碳源对烟草叶斑病病原菌菌丝生长的影响
2.10. 不同氮源对烟草叶斑病病原菌菌丝生长的影响
-
本研究证实了P. bulgarica可引起烟草叶斑病,该病害在烤烟圆顶期至打脚叶前后发生,典型症状为叶缘和叶尖呈“锯齿状”,具明显的黄绿色晕圈。在生产上常被误认为是昆虫危害造成的缺刻或孔洞,加之防治策略不合理,影响烟草的生产。2024年8月,在陕西省其他烤烟产区不同品系(种)烟株叶片上也发现了此病害,该新型叶斑病的发生,严重影响了烟叶的产量和烤烟的外观品质,需高度重视。研究人员可通过设计特异性引物等[20]方法精准诊断,确定预防该叶斑病的最佳时期,精准用药,同时采取其他有效措施加以防治。
Phoma属真菌,种类多,可引起多种植物病害,病原菌的鉴定较为困难[21-22]。通过ITS、LSU和TUB2多基因系统发育树分析,我们初步确定烟草叶斑病的病原菌BAN1为P. bulgarica。P. bulgarica属子囊菌门,Aveskamp等[23]报道其从紫草科植物Trachystemon orientale分离得到,分生孢子器在添加灭菌异株荨麻(Urtica dioica L.)的MEA培养基上产生,P. bulgarica CBS 258.92分生孢子器大小为(140~170) μm×(250~295) μm,在OA培养基上培养7 d的菌落直径为45~65 mm;在MEA培养基上培养7 d的菌落直径为40~45 mm,且不同菌株间菌落形态存在差异。本研究结果与Aveskamp等[23]的研究不完全一致,分生孢子器形态相似,大小略有差异;在OA和MEA培养基上菌丝生长速率相似,菌落颜色略有不同,可能是由于寄主、地理位置、环境条件、试验技术等不同造成的。
P. bulgarica BAN1生物学特性结果表明,PDA培养基、25 ℃、全黑暗条件更利于病原菌的生长。该病原菌生长最适pH值为5,适宜生长温度为20~25 ℃,致死温度为46 ℃、水浴10 min。这与当地土壤偏酸性,田间发病时降雨、温湿度条件相对应。在生产上可通过控制田间密度、及时清除脚叶增加透光透气性,加强田间管理,及时采取化学、生物等防治方法[24]对烟草叶斑病进行综合防控,降低病害造成的经济损失。目前尚未见关于该病原菌生物学特性的报道,后续我们将对其产孢特性、孢子萌发条件、化学药剂及生防菌的筛选展开进一步的研究。
本研究鉴定了一种烟草新叶斑病的病原菌,这是在国内首次报道由P. bulgarica引起的烟草叶斑病,明确了该病原菌对于生长环境条件及其营养的需求,结果将为该病害的进一步诊断、预测以及流行规律研究与综合防治策略的制定提供基础。




 下载:
下载: